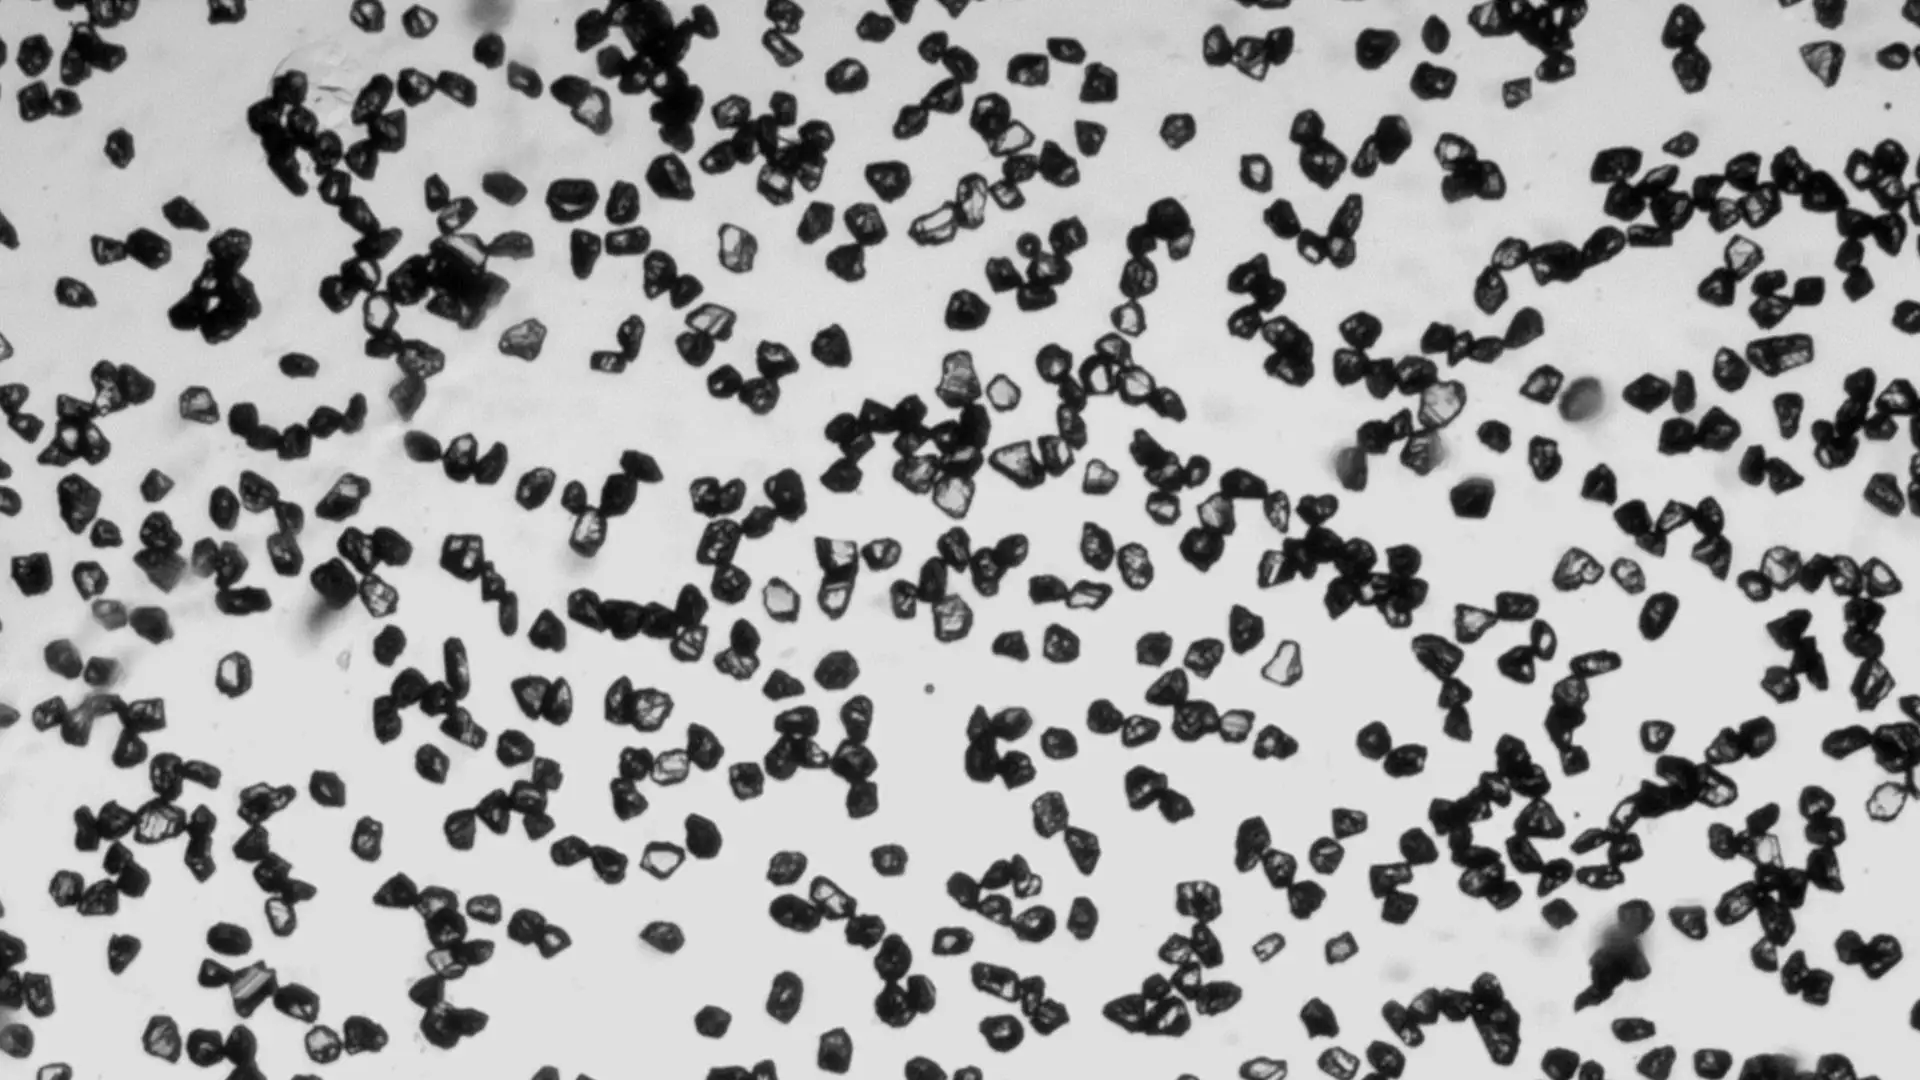

High Purity russian synthetic diamond industrial price for gemstone
- Категории: Welding & Abrasives >>>
- Поставщик: Henan,Boreas,New,Material,Co.,Ltd.
Поделиться:
Описание и отзывы
Характеристики

Brief Description Diamond Micro Powder
BOREAS synthetic diamond powder is made of the high-quality synthetic diamond as raw material, through many different and strict production processes. Our diamond powder can be processed and applied to the different industries for cutting, grinding, drilling and polishing usage, in order to match the different requirements.Detailed Image

Product Paramenters
Standard of China | Standard of international | Mesh | Polishing effect | Standard of China | Standard of international | Mesh | Polishing effect |
w0.25 | 0-0.25 | 60000 | Super mirror polishing | w10 | 5-10 | 2000 | Normal polishing |
w0.5 | 0-0.5 | 30000 | Mirror polishing | w10+ | 6-12 | 1800 | |
w1 | 0-1 | 15000 | Mirror polishing | w12 | 8-12 | 1600 | |
w1.5- | 0-2 | 13000 | w14 | 7-14 | 1500 | ||
w1.5 | 1-2 | 12000 | Fine polishing | w14 | 8-16 | 1300 | |
w2.5 | 1-3 | 10000 | w20- | 10-20 | 1200 | ||
w3 | 2-3 | 7000 | w20 | 12-22 | 1000 | ||
w3.5 | 2-4- | 6500 | w20+ | 15-25 | 800 | ||
w3.5 | 2-4 | 6000 | w28 | 20-30 | 700 | ||
w4 | 2-5 | 5000 | w28+ | 22-36 | 600 | ||
w5 | 3-6 | 4000 | w40- | 20-40 | 500 | Rough grinding | |
w6 | 4-6 | 3500 | w40 | 30-40 | 450 | ||
w7 | 4-8 | 3000 | Normal polishing | w40+ | 35-45 | 400 | |
w10- | 4-9 | 2500 | w50 | 36-54 |
Products Description

Product Application

Product Process

Company Profile

Payment&Shipping&Packing























